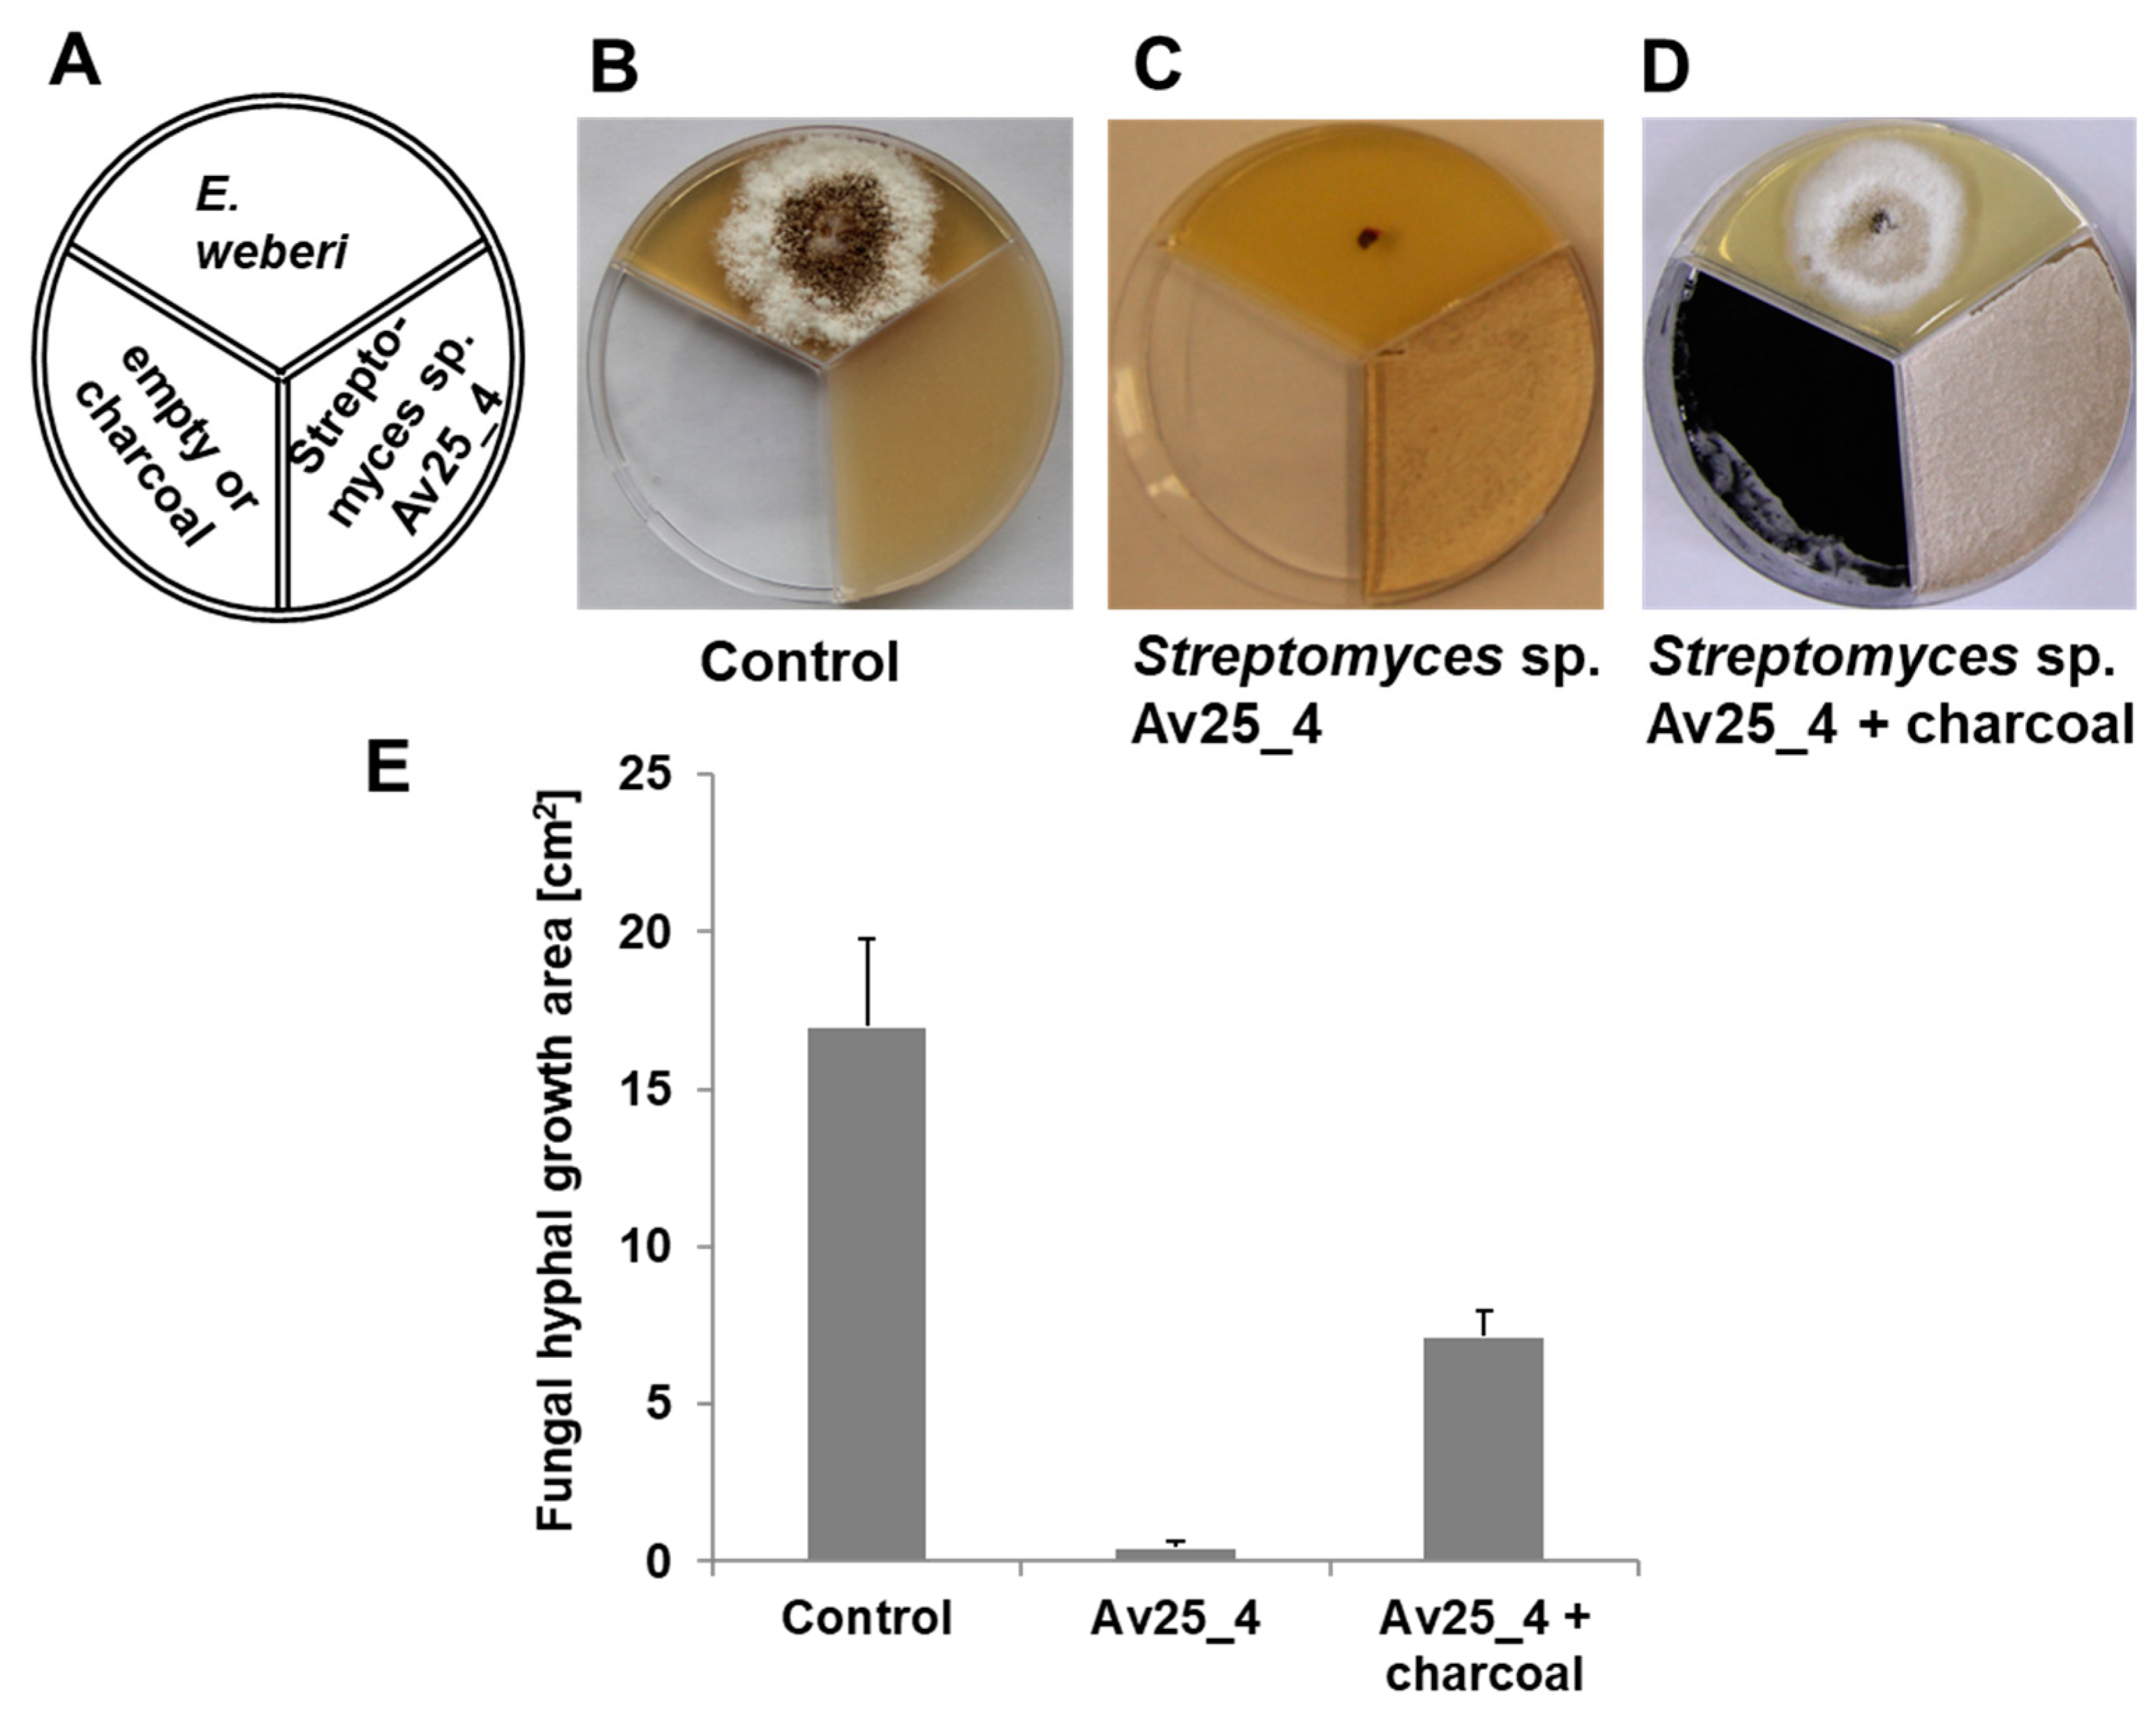
Microorganisms 09 01622 g002

Ammonia Production by Streptomyces Symbionts of Acromyrmex Leaf-Cutting Ants Strongly Inhibits the Fungal Pathogen Escovopsis
Abstract
:1. Introduction
2. Materials and Methods
2.1. Chemicals
2.2. Streptomyces Symbionts, Fungal Strains and Cultivation Conditions
2.3. Screening Streptomyces Symbionts for Antifungal Volatile Compounds
2.4. Trapping Volatiles Released by Streptomyces sp. Av25_4 and Evaluation of the Consequences on E. weberi Growth
2.5. Closed Loop Stripping (CLS) of Volatiles: GC-MS Analysis and Bioassays with the Collected Organic Volatiles
2.6. Change of the pH upon Growth of Streptomyces sp. Av25_4
2.7. Detection of Ammonia
2.8. Quantification of Ammonia
2.9. Influence of Ammonia on the Growth of E. weberi, E. aspergilloides, F. equiseti, and L. gongylophorus
2.10. Influence of Medium Alkalinization on the Growth of E. weberi
2.11. Determination of the pH and Quantification of Ammonia from Waste of Leaf-Cutting Ants
3. Results
3.1. Streptomyces sp. Av25_4 Produces Antifungal Volatiles
3.2. Analysis of Volatiles from Streptomyces sp. Av25_4
3.3. Streptomyces sp. Av25_4 Overproduces Ammonia
3.4. Ammonia from Streptomyces sp. Av25_4 Strongly Inhibits the Growth of Escovopsis
3.5. Alkalinization of the Medium and Growth Inhibition
3.6. Waste of Leaf-cutting Ants Can Be Strongly Basic
4. Discussion
Supplementary Materials
Author Contributions
Funding
Data Availability Statement
Acknowledgments
Conflicts of Interest
References
- Hölldobler, B.; Wilson, E.O. The Ants; Harvard University Press: Cambridge, MA, USA, 1990. [Google Scholar]
- Wirth, R.; Beyschlag, W.; Ryel, R.; Herz, H.; Hölldobler, B. The Herbivory of Leaf-Cutting Ants. In A Case Study on Atta Colombica in the Tropical Rainforest of Panama; Springer: Berlin/Heidelberg, Germany; New York, NY, USA, 2003. [Google Scholar]
- Silva, A.; Bacci, M., Jr.; Gomes de Siqueira, C.; Correa Bueno, O.; Pagnocca, F.C.; Aparecida Hebling, M.J. Survival of Atta sexdens workers on different food sources. J. Insect. Physiol. 2003, 49, 307–313. [Google Scholar] [CrossRef]
- Aylward, F.O.; Burnum-Johnson, K.E.; Tringe, S.G.; Teiling, C.; Tremmel, D.M.; Moeller, J.A.; Scott, J.J.; Barry, K.W.; Piehowski, P.D.; Nicora, C.D.; et al. Leucoagaricus gongylophorus produces diverse enzymes for the degradation of recalcitrant plant polymers in leaf-cutter ant fungus gardens. Appl. Environ. Microbiol. 2013, 79, 3770–3778. [Google Scholar] [CrossRef] [PubMed] [Green Version]
- Fisher, P.J.; Stradling, D.J.; Sutton, B.C.; Petrini, L.E. Microfungi in the fungus gardens of the leaf-cutting ant Atta cephalotes: A preliminary study. Mycol. Res. 1996, 100, 541–546. [Google Scholar] [CrossRef]
- Currie, C.R.; Mueller, U.G.; Malloch, D. The agricultural pathology of ant fungus gardens. Proc. Natl. Acad. Sci. USA 1999, 96, 7998–8002. [Google Scholar] [CrossRef] [Green Version]
- Bot, A.N.M.; Currie, C.R.; Hart, A.G.; Boomsma, J. Waste management in leaf-cutting ants. Ethol. Ecol. Evol. 2001, 13, 225–237. [Google Scholar] [CrossRef]
- Muchovej, J.J.; Della Lucia, T.M. Escovopsis, a new genus from leaf-cutting ant nests to replace Phialocladus nomem invalidum. Mycotaxon 1990, 37, 191–195. [Google Scholar]
- Seifert, K.A.; Samson, R.A.; Chapela, I.H. Escovopsis aspergilloides, a rediscovered hyphomycete from leaf-cutting ant nests. Mycologia 1995, 87, 407–413. [Google Scholar] [CrossRef]
- Rodrigues, A.; Pagnocca, F.; Bacci, M.; Hebling, M.; Bueno, O.; Pfenning, L. Variability of non-mutualistic filamentous fungi associated with Atta sexdens rubropilosa nests. Folia Microbiol. 2005, 50, 421. [Google Scholar] [CrossRef]
- Boya, P.C.; Fernandez-Marin, H.; Mejia, L.C.; Spadafora, C.; Dorrestein, P.C.; Gutierrez, M. Imaging mass spectrometry and MS/MS molecular networking reveals chemical interactions among cuticular bacteria and pathogenic fungi associated with fungus-growing ants. Sci. Rep. 2017, 7, 5604. [Google Scholar] [CrossRef] [PubMed] [Green Version]
- Dhodary, B.; Schilg, M.; Wirth, R.; Spiteller, D. Secondary Metabolites from Escovopsis weberi and Their Role in Attacking the Garden Fungus of Leaf-Cutting Ants. Chemistry 2018, 24, 4445–4452. [Google Scholar] [CrossRef] [PubMed] [Green Version]
- Heine, D.; Holmes, N.A.; Worsley, S.F.; Santos, A.C.A.; Innocent, T.M.; Scherlach, K.; Patrick, E.H.; Yu, D.W.; Murrell, J.C.; Vieria, P.C.; et al. Chemical warfare between leafcutter ant symbionts and a co-evolved pathogen. Nat. Commun. 2018, 9, 2208. [Google Scholar] [CrossRef]
- Schildknecht, H.; Koob, K. Myrmicacin, the first insect herbicide. Angew. Chem. Int. Ed. 1971, 10, 124–125. [Google Scholar] [CrossRef]
- Ortius-Lechner, D.; Maile, R.; Morgan, E.D.; Boomsma, J.J. Metapleural gland secretion of the leaf-cutter ant Acromyrmex octospinosus: New compounds and their functional significance. J. Chem. Ecol. 2000, 26, 1667–1683. [Google Scholar] [CrossRef]
- Bot, A.N.M.; Ortius-Lechner, D.; Finster, K.; Maile, R.; Boomsma, J.J. Variable sensitivity of fungi and bacteria to compounds produced by the metapleural glands of leaf-cutting ants. Insect. Soc. 2002, 49, 363–370. [Google Scholar] [CrossRef]
- Fernández-Marín, H.; Zimmerman, J.K.; Rehner, S.A.; Wcislo, W.T. Active use of the metapleural glands by ants in controlling fungal infection. Proc. Roy. Soc. B Biol. Sci. 2006, 273, 1689–1695. [Google Scholar] [CrossRef] [PubMed] [Green Version]
- Fernández-Marín, H.; Nash, D.R.; Higginbotham, S.; Estrada, C.; van Zweden, J.S.; d’Ettorre, P.; Wcislo, W.T.; Boomsma, J.J. Functional role of phenylacetic acid from metapleural gland secretions in controlling fungal pathogens in evolutionarily derived leaf-cutting ants. Proc. Roy. Soc. B Biol. Sci. 2015, 282, 20150212. [Google Scholar] [CrossRef] [PubMed]
- Currie, C.R.; Scott, J.A.; Summerbell, R.C.; Malloch, D. Fungus-growing ants use antibiotic-producing bacteria to control garden parasites. Nature 1999, 398, 701–704. [Google Scholar] [CrossRef]
- Santos, A.V.; Dillon, R.J.; Dillon, V.M.; Reynolds, S.E.; Samuels, R.I. Ocurrence of the antibiotic producing bacterium Burkholderia sp. in colonies of the leaf-cutting ant Atta sexdens rubropilosa. FEMS Microbiol. Lett. 2004, 239, 319–323. [Google Scholar] [CrossRef] [PubMed] [Green Version]
- Kost, C.; Lakatos, T.; Böttcher, I.; Arendholz, W.R.; Redenbach, M.; Wirth, R. Non-specific association between filamentous bacteria and fungus-growing ants. Naturwissenschaften 2007, 94, 821–828. [Google Scholar] [CrossRef] [PubMed]
- Haeder, S.; Wirth, R.; Herz, H.; Spiteller, D. Candicidin-producing Streptomyces support leaf-cutting ants to protect their fungus garden against the pathogenic fungus Escovopsis. Proc. Natl. Acad. Sci. USA 2009, 106, 4742–4746. [Google Scholar] [CrossRef] [Green Version]
- Oh, D.-C.; Poulsen, M.; Currie, C.R.; Clardy, J. Dentigerumycin: A bacterial mediator of an ant-fungus symbiosis. Nature Chem. Biol. 2009, 5, 391–393. [Google Scholar] [CrossRef] [PubMed]
- Pinto-Tomas, A.A.; Anderson, M.A.; Suen, G.; Stevenson, D.M.; Chu, F.S.T.; Cleland, W.W.; Weimer, P.J.; Currie, C.R. Symbiotic nitrogen fixation in the fungus gardens of leaf-cutter ants. Science 2009, 326, 1120–1123. [Google Scholar] [CrossRef] [PubMed]
- Barke, J.; Seipke, R.F.; Grüschow, S.; Heavens, D.; Drou, N.; Bibb, M.J.; Goss, R.J.M.; Yu, D.W.; Hutchings, M.I. A mixed community of actinomycetes produce multiple antibiotics for the fungus farming ant Acromyrmex octospinosus. BMC Biol. 2010, 8, 109. [Google Scholar] [CrossRef] [Green Version]
- Holmes, N.A.; Innocent, T.M.; Heine, D.; Bassam, M.A.; Worsley, S.F.; Trottmann, F.; Patrick, E.H.; Yu, D.W.; Murrell, J.C.; Schiøtt, M. Genome analysis of two Pseudonocardia phylotypes associated with Acromyrmex leafcutter ants reveals their biosynthetic potential. Front. Microbiol. 2016, 7, 2073. [Google Scholar] [CrossRef] [PubMed] [Green Version]
- Schoenian, I.; Spiteller, M.; Ghaste, M.; Wirth, R.; Herz, H.; Spiteller, D. Chemical basis of the synergism and antagonism in microbial communities in the nests of leaf-cutting ants. Proc. Natl. Acad. Sci. USA 2011, 108, 1955–1960. [Google Scholar] [CrossRef] [Green Version]
- Seipke, R.F.; Barke, J.; Brearley, C.; Hill, L.; Yu, D.W.; Goss, R.J.M.; Hutchings, M.I. A single Streptomyces symbiont makes multiple antifungals to support the fungus farming ant Acromyrmex octospinosus. PLoS ONE 2011, 6, e22028. [Google Scholar] [CrossRef] [Green Version]
- Fukuda, T.T.H.; Helfrich, E.J.N.; Mevers, E.; Melo, W.G.P.; Van Arnam, E.B.; Andes, D.R.; Currie, C.R.; Pupo, M.T.; Clardy, J. Specialized Metabolites Reveal Evolutionary History and Geographic Dispersion of a Multilateral Symbiosis. ACS Cent. Sci. 2021, 7, 292–299. [Google Scholar] [CrossRef] [PubMed]
- Kieser, T.E.; Bibb, M.J.; Buttner, M.J.; Chater, K.F.; Hopwood, D.A. Practical Streptomyces Genetics; John Innes Foundation: Colney, UK, 2000. [Google Scholar]
- Grob, K. Organic substances in potable water and in its precursor: Part I. Methods for their determination by gas-liquid chromatography. J. Chrom. A 1973, 84, 255–273. [Google Scholar] [CrossRef]
- Avalos, M.; Garbeva, P.; Raaijmakers, J.M.; van Wezel, G.P. Production of ammonia as a low-cost and long-distance antibiotic strategy by Streptomyces species. ISME J. 2019, 1–15. [Google Scholar] [CrossRef]
- Genfa, Z.; Dasgupta, P.K. Fluorometric measurement of aqueous ammonium ion in a flow injection system. Anal. Chem. 1989, 61, 408–412. [Google Scholar] [CrossRef]
- Schmidt, K.; Spiteller, D. Ammonia released by Streptomyces aburaviensis induces droplet formation in Streptomyces violaceoruber. J. Chem. Ecol. 2017, 43, 806–816. [Google Scholar] [CrossRef] [Green Version]
- Schulz, S.; Dickschat, J.S. Bacterial volatiles: The smell of small organisms. Nat. Prod. Rep. 2007, 24, 814–842. [Google Scholar] [CrossRef]
- Schmidt, R.; Cordovez, V.; De Boer, W.; Raaijmakers, J.; Garbeva, P. Volatile affairs in microbial interactions. ISME J. 2015, 9, 2329–2335. [Google Scholar] [CrossRef] [Green Version]
- Avalos, M.; van Wezel, G.P.; Raaijmakers, J.M.; Garbeva, P. Healthy scents: Microbial volatiles as new frontier in antibiotic research? Curr. Opin. Microbiol. 2018, 45, 84–91. [Google Scholar] [CrossRef] [Green Version]
- Jones, S.E.; Ho, L.; Rees, C.A.; Hill, J.E.; Nodwell, J.R.; Elliot, M.A. Streptomyces exploration is triggered by fungal interactions and volatile signals. Elife 2017, 6, e21738. [Google Scholar] [CrossRef]
- Gürtler, H.; Pedersen, R.; Anthoni, U.; Christophersen, C.; Nielsen, P.H.; Wellington, E.M.H.; Pedersen, C.; Bock, K. Albaflavenone, a sesquiterpene ketone with a zizaene skeleton produced by a streptomycete with a new rope morphology. J. Antibiot. 1994, 47, 434–439. [Google Scholar] [CrossRef] [PubMed] [Green Version]
- Huang, H.; Ren, L.; Li, H.; Schmidt, A.; Gershenzon, J.; Lu, Y.; Cheng, D. The nesting preference of an invasive ant is associated with the cues produced by actinobacteria in soil. PLoS Pathog. 2020, 16, e1008800. [Google Scholar] [CrossRef] [PubMed]
- Silva-Junior, E.A.; Ruzzini, A.C.; Paludo, C.R.; Nascimento, F.S.; Currie, C.R.; Clardy, J.; Pupo, M.T. Pyrazines from bacteria and ants: Convergent chemistry within an ecological niche. Sci. Rep. 2018, 8, 2595. [Google Scholar] [CrossRef] [Green Version]
- Evershed, R.; Morgan, E. The amounts of trail pheromone substances in the venom of workers of four species of attine ants. Insect Biochem. 1983, 13, 469–474. [Google Scholar] [CrossRef]
- Cross, J.H.; West, J.R.; Silverstein, R.M.; Jutsum, A.R.; Cherrett, J.M. Trail pheromone of the leaf-cutting ant, Acromyrmex octospinosus (Reich),(Formicidae: Myrmicinae). J. Chem. Ecol. 1982, 8, 1119–1124. [Google Scholar] [CrossRef]
- de Oliveira, J.; Martinez, O.; Carnieri, N.; Vilela, E.; Reis, H. Components of the trail pheromone of the leaf-cutting ants Atta laevigata F. Smith and Atta bisphaerica Forel (Formicidae: Attini). An. Soc. Entomológica Bras. 1990, 19, 145–154. [Google Scholar]
- Howell, C.R.; Beier, R.C.; Stipanovic, R.D. Production of Ammonia by Enterobacter cloacae and Its Possible Role in the Biological Control of Pythium Preemergence Damping-off by the Bacterium. Phytopathology 1988, 78, 1075–1078. [Google Scholar] [CrossRef]
- Somera, A.F.; Lima, A.M.; Dos Santos-Neto, A.J.; Lancas, F.M.; Bacci, M., Jr. Leaf-cutter ant fungus gardens are biphasic mixed microbial bioreactors that convert plant biomass to polyols with biotechnological applications. Appl. Environ. Microbiol. 2015, 81, 4525–4535. [Google Scholar] [CrossRef] [PubMed] [Green Version]
- Semenova, T.A.; Hughes, D.P.; Boomsma, J.J.; Schiott, M. Evolutionary patterns of proteinase activity in attine ant fungus gardens. BMC Microbiol. 2011, 11, 15. [Google Scholar] [CrossRef] [Green Version]
- Parkouda, C.; Nielsen, D.S.; Azokpota, P.; Ouoba, L.I.; Amoa-Awua, W.K.; Thorsen, L.; Hounhouigan, J.D.; Jensen, J.S.; Tano-Debrah, K.; Diawara, B.; et al. The microbiology of alkaline-fermentation of indigenous seeds used as food condiments in Africa and Asia. Crit. Rev. Microbiol. 2009, 35, 139–156. [Google Scholar] [CrossRef] [PubMed]
- De Roos, J.; De Vuyst, L. Acetic acid bacteria in fermented foods and beverages. Curr. Opin. Biotechnol. 2018, 49, 115–119. [Google Scholar] [CrossRef] [PubMed]

Publisher’s Note: MDPI stays neutral with regard to jurisdictional claims in published maps and institutional affiliations. |
© 2021 by the authors. Licensee MDPI, Basel, Switzerland. This article is an open access article distributed under the terms and conditions of the Creative Commons Attribution (CC BY) license (https://creativecommons.org/licenses/by/4.0/).
Share and Cite
Dhodary, B.; Spiteller, D. Ammonia Production by Streptomyces Symbionts of Acromyrmex Leaf-Cutting Ants Strongly Inhibits the Fungal Pathogen Escovopsis. Microorganisms 2021, 9, 1622. https://doi.org/10.3390/microorganisms9081622
Dhodary B, Spiteller D. Ammonia Production by Streptomyces Symbionts of Acromyrmex Leaf-Cutting Ants Strongly Inhibits the Fungal Pathogen Escovopsis. Microorganisms. 2021; 9(8):1622. https://doi.org/10.3390/microorganisms9081622
Chicago/Turabian StyleDhodary, Basanta, and Dieter Spiteller. 2021. "Ammonia Production by Streptomyces Symbionts of Acromyrmex Leaf-Cutting Ants Strongly Inhibits the Fungal Pathogen Escovopsis" Microorganisms 9, no. 8: 1622. https://doi.org/10.3390/microorganisms9081622
APA StyleDhodary, B., & Spiteller, D. (2021). Ammonia Production by Streptomyces Symbionts of Acromyrmex Leaf-Cutting Ants Strongly Inhibits the Fungal Pathogen Escovopsis. Microorganisms, 9(8), 1622. https://doi.org/10.3390/microorganisms9081622
